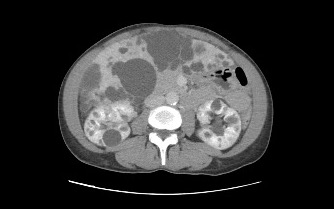

Hay estudios que empiezan como algo completamente rutinario… y terminan contándonos una historia clínica muy completa. Este es uno de esos casos que tanto nos enseñan en la práctica diaria.
Se trata de un paciente de mediana edad que acude a consulta para una revisión general. Refiere molestias abdominales, de predominio postprandial, sin otra clínica llamativa. Ante este cuadro, su médico de familia solicita una ecografía abdominal rutinaria.
Y ahí comienza lo interesante.
Exploración Abdominal, protocolo habitual.
En la exploración ecográfica abdominal realizamos siempre el estudio completo del abdomen, siguiendo un orden sistemático que nos permita no pasar nada por alto.
Habitualmente comenzamos por:
- Páncreas
- Hígado
Dentro del estudio hepático valoramos de forma protocolizada:
- Sistema porta
- Venas suprahepáticas
- Vesícula biliar
- Unión hepatorrenal (imagen clave)
Esta comparación entre el parénquima hepático y el parénquima renal es especialmente importante y forma parte imprescindible de cualquier protocolo bien realizado.
Posteriormente continuamos con:
- Riñón derecho
- Riñón izquierdo
- Áreas suprarrenales
- Bazo
Después realizamos la exploración de la región medial del abdomen, desde el apéndice xifoides hasta la sínfisis púbica, valorando:
- Aorta abdominal
- Vena cava inferior
- Espacio retroperitoneal
Y finalizamos con la valoración de la pelvis menor:
- Vejiga urinaria
- Anejos en la mujer
- Próstata en el varón
Este es, de forma resumida, el protocolo general de abdomen completo que todo estudio ecográfico debe incluir.
Inicio del caso
En este caso iniciamos la exploración con sonda convex, siguiendo el protocolo habitual de ecografía abdominal y, al valorar el parénquima hepático, rápidamente llama la atención un hallazgo muy característico que es el que pasamos a describir a continuación.
- Número prácticamente incontable de lesiones
- Morfología redondeada
- Contenido anecoico
- Bordes finos, lisos y bien definidos
El patrón era bastante típico y, según el criterio del radiólogo, correspondía a múltiples quistes hepáticos, como queda reflejado en las imágenes ecográficas (imagen 1 e imagen 2).


Una lesión distinta…
Durante el mismo estudio hepático se identifica una lesión que no sigue exactamente el comportamiento del resto:
- Más ecogénica
- Con contenido interno
- No completamente anecoica
El radiólogo la interpreta como posible quiste hepático complicado, como ves en las imágenes siguientes, siempre, documentar lo mejor posible.
Conviene recordar que en los cuadros de poliquistosis hepática o hepatorrenal algunos quistes pueden sangrar, infectarse o modificar su contenido, perdiendo el aspecto anecoico puro y mostrando ecos internos o mayor ecogenicidad. Debemos estar muy atentos a cualquier cambio y mirar muy bien gastando tiempo en revisar todo.


Evaluación renal dentro del protocolo abdominal
Como parte de la misma exploración del protocolo de ecografía abdominal, se procede al estudio de ambos riñones.
En ellos se detectan:
- Múltiples lesiones anecoicas
- Morfología redondeada
- Distribuidas por el parénquima renal de ambos riñones


Actuación ante hallazgos no habituales
Una vez realizada la exploración siguiendo el protocolo habitual y tras objetivar los hallazgos previamente descritos, es importante recordar cuál debe ser nuestra actuación correcta como técnicos ecografistas.
Ante cualquier hallazgo que:
- Nos resulte inusual
- No cumpla criterios de normalidad
- O nos genere duda
Lo primero, documentarlo todo muy bien, usando todas las herramientas técnicas de la que disponga el equipo.
Lo segundo que debemos hacer —siempre— es ponerlo en conocimiento del médico radiólogo.
Este punto es clave dentro de la buena práctica profesional.
Comunicación con el radiólogo
En este caso se actuó siguiendo el protocolo de actuación correcta. Se avisó al radiólogo responsable para que evaluase las imágenes obtenidas durante la ecografía abdominal.
Tras la revisión, y con los hallazgos disponibles, el radiólogo planteó como primera posibilidad diagnóstica una:
👉 Poliquistosis hepatorrenal
👉 Con probable complicación de uno de los quistes hepáticos
Con esta orientación, el radiólogo realizó su informe correspondiente y el paciente fue remitido a su médico de atención primaria.
Un punto clave: el componente genético. Un dato a tener en cuenta.
La poliquistosis hepatorrenal es una patología de predominio genético, y este aspecto no debe pasarse por alto.
Esto implica que:
- Otros miembros de la familia podrían padecer la enfermedad
- Se recomienda valoración familiar
- La ecografía de cribado puede ser muy útil para descartar afectación en familiares directos
Desde el punto de vista clínico, este paso es tan importante como el propio diagnóstico individual.
Ampliación del estudio: TAC abdominal
Debido a la presencia del quiste hepático de aspecto atípico, el especialista decide ampliar el estudio mediante TAC abdominal.
En los cortes axiales y coronales se observa con claridad:
- Múltiples quistes en el parénquima hepático
- Quistes renales bilaterales
- La lesión hepática previamente descrita
El TAC permite confirmar la extensión hepatorrenal de la enfermedad y caracterizar mejor las lesiones.

Resonancia magnética hepática: confirmación definitiva
Para completar la caracterización, se realiza resonancia magnética hepática.
Los hallazgos son muy ilustrativos:
- Gran cantidad de quistes hepáticos y renales
- En secuencias T2: lesiones marcadamente hiperintensas (muy brillantes)
- En el plano coronal: ocupación extensa del parénquima hepático y renal
La RM confirma de forma elegante la naturaleza quística de la mayoría de las lesiones.

El detalle fino: la aportación de la sonda lineal
Como parte del protocolo ecográfico, además de la sonda convex se realizó exploración con sonda lineal de alta frecuencia, especialmente útil en hígado superficial.
Aquí apareció un hallazgo muy interesante:
- Múltiples lesiones hiperecogénicas redondeadas
- Distribuidas por el parénquima hepático
- Coexistiendo con los quistes hepáticos
Fue un hallazgo casual, pero muy bien demostrado en la última imagen del estudio. Esta coexistencia entre lesiones quísticas y lesiones sólidas hiperecogénicas no había quedado inicialmente descritas y pone en valor la importancia de complementar la exploración.

Diagnóstico final
El Radiólogo concluye con un diagnóstico de:
Poliquistosis hepatorrenal con:
- Afectación hepática masiva
- Afectación renal bilateral
- Probable quiste hepático complicado
- Hallazgo incidental de lesiones hepáticas hiperecogénicas múltiples
Reflexión para la práctica
Este caso nos recuerda varias cosas que en ecografía conviene no olvidar:
- La poliquistosis hepática con frecuencia es un hallazgo incidental.
- No todos los quistes mantienen el aspecto anecoico típico.
- La presencia de ecos internos obliga a ampliar estudio.
- El protocolo abdominal debe ser siempre completo.
- Y la sonda lineal en hígado superficial puede aportar información de gran valor.